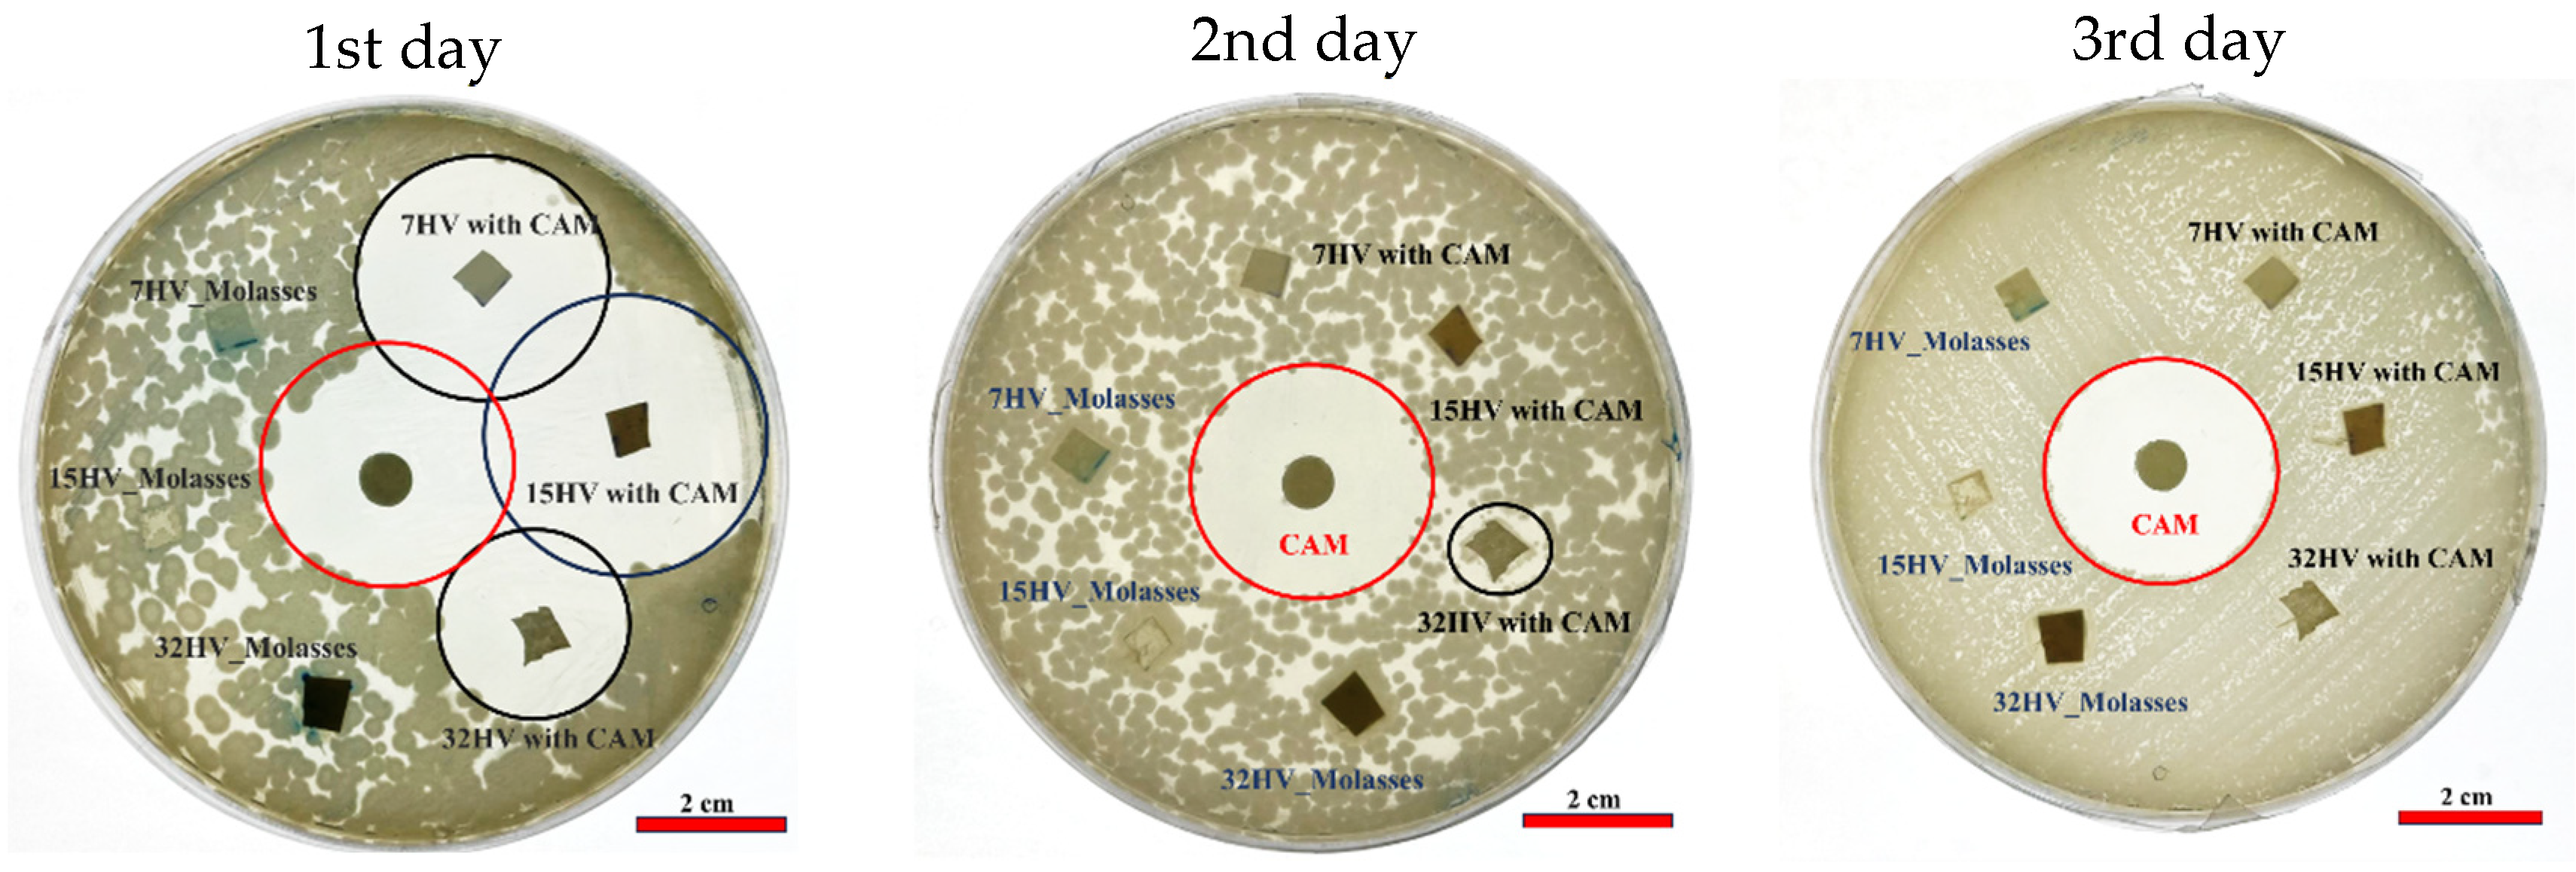
Ijms 26 00180 g014

Characterization and Biomedical Applications of Electrospun PHBV Scaffolds Derived from Organic Residues
Abstract
1. Introduction
2. Results and Discussion
2.1. Structural Analysis of PHBV Samples
2.1.1. FTIR Analysis
2.1.2. XRD Results
2.1.3. NMR Analysis
2.2. Thermal Behavior of PHBV Samples
2.2.1. DSC Calorimetric Data
2.2.2. Thermal Degradation of PHBV Samples
2.3. Mechanical Properties of the PHBV Samples
2.4. PHBV Electrospun Fibers
2.4.1. Electrospinning Process Optimization
2.4.2. Degradation During the Electrospinning Process
2.4.3. Morphology of PHBV Electrospun Fibers
2.4.4. Thermal Behavior of PHBV Electrospun Fibers
2.5. In Vitro Drug Release of PHBV Scaffolds
2.6. Antibacterial Activity of PHBV Scaffolds
2.7. Cytotoxicity Evaluation of PHBV Scaffolds
3. Materials and Methods
3.1. PHBV Samples
3.2. Characterization of PHBV Samples
3.2.1. Molar Mass Determination
3.2.2. FTIR Spectral Analysis
3.2.3. NMR Spectroscopy
3.2.4. Thermal Analysis
3.2.5. Mechanical Analysis
3.3. Fabrication of PHBV Electrospun Fibers
3.4. Morphological and Physical Characterization of Scaffolds
3.4.1. SEM Analysis of PHBV Electrospun Fibers
3.4.2. XRD Analysis of PHBV Electrospun Fibers
3.5. Biological Studies of PHBV Electrospun Fibers
3.5.1. In Vitro Drug Release from PHBV Electrospun Fibers
3.5.2. Antibacterial Activity
3.5.3. Cytotoxicity Evaluation
4. Conclusions
Supplementary Materials
Author Contributions
Funding
Institutional Review Board Statement
Informed Consent Statement
Data Availability Statement
Acknowledgments
Conflicts of Interest
References
- Steinbüchel, A.; Valentin, H.E. Diversity of Bacterial Polyhydroxyalkanoic Acids. FEMS Microbiol. Lett. 1995, 128, 219–228. [Google Scholar] [CrossRef]
- Steinbüchel, A.; Füchtenbusch, B. Bacterial and Other Biological Systems for Polyester Production. Trends Biotechnol. 1998, 16, 419–427. [Google Scholar] [CrossRef] [PubMed]
- Acharjee, S.A.; Bharali, P.; Gogoi, B.; Sorhie, V.; Walling, B.; Alemtoshi. PHA-Based Bioplastic: A Potential Alternative to Address Microplastic Pollution. Water Air Soil. Pollut. 2023, 234, 21. [Google Scholar] [CrossRef]
- Wang, S.; Chen, W.; Xiang, H.; Yang, J.; Zhou, Z.; Zhu, M. Modification and Potential Application of Short-Chain-Length Polyhydroxyalkanoate (SCL-PHA). Polymers 2016, 8, 273. [Google Scholar] [CrossRef]
- Abbasi, M.; Pokhrel, D.; Coats, E.R.; Guho, N.M.; McDonald, A.G. Effect of 3-Hydroxyvalerate Content on Thermal, Mechanical, and Rheological Properties of Poly(3-Hydroxybutyrate-Co-3-Hydroxyvalerate) Biopolymers Produced from Fermented Dairy Manure. Polymers 2022, 14, 4140. [Google Scholar] [CrossRef] [PubMed]
- Policastro, G.; Panico, A.; Fabbricino, M. Improving Biological Production of Poly(3-Hydroxybutyrate-Co-3-Hydroxyvalerate) (PHBV) Co-Polymer: A Critical Review. Rev. Environ. Sci. Biotechnol. 2021, 20, 479–513. [Google Scholar] [CrossRef]
- Urtuvia, V.; Maturana, N.; Peña, C.; Díaz-Barrera, A. Accumulation of Poly(3-Hydroxybutyrate-Co-3-Hydroxyvalerate) by Azotobacter Vinelandii with Different 3HV Fraction in Shake Flasks and Bioreactor. Bioprocess Biosyst. Eng. 2020, 43, 1469–1478. [Google Scholar] [CrossRef] [PubMed]
- Berezina, N.; Yada, B. Improvement of the Poly(3-Hydroxybutyrate-Co-3-Hydroxyvalerate) (PHBV) Production by Dual Feeding with Levulinic Acid and Sodium Propionate in Cupriavidus Necator. N. Biotechnol. 2016, 33, 231–236. [Google Scholar] [CrossRef]
- Aramvash, A.; Hajizadeh-Turchi, S.; Moazzeni-zavareh, F.; Gholami-Banadkuki, N.; Malek-sabet, N.; Akbari-Shahabi, Z. Effective Enhancement of Hydroxyvalerate Content of PHBV in Cupriavidus Necator and Its Characterization. Int. J. Biol. Macromol. 2016, 87, 397–404. [Google Scholar] [CrossRef]
- Ganzeveld, K.J.; van Hagen, A.; van Agteren, M.H.; de Koning, W.; Uiterkamp, A.J.S. Upgrading of Organic Waste: Production of the Copolymer Poly-3-Hydroxybutyrate-Co-Valerate by Ralstonia Eutrophus with Organic Waste as Sole Carbon Source. J. Clean. Prod. 1999, 7, 413–419. [Google Scholar] [CrossRef]
- Serafim, L.S.; Lemos, P.C.; Albuquerque, M.G.E.; Reis, M.A.M. Strategies for PHA Production by Mixed Cultures and Renewable Waste Materials. Appl. Microbiol. Biotechnol. 2008, 81, 615–628. [Google Scholar] [CrossRef] [PubMed]
- Wang, J.; Liu, S.; Huang, J.; Qu, Z. A Review on Polyhydroxyalkanoate Production from Agricultural Waste Biomass: Development, Advances, Circular Approach, and Challenges. Bioresour. Technol. 2021, 342, 126008. [Google Scholar] [CrossRef] [PubMed]
- Chanasit, W.; Bunkaew, K. Inexpensive Production of Poly (3-hydroxybutyrate-co-3-hydroxyvalerate) from Bacillus Megaterium PP-10 Using Pineapple Peel Waste. ASEAN J. Sci. Technol. Rep. 2023, 26, 36–44. [Google Scholar] [CrossRef]
- Gheibi, A.; Khoshnevisan, K.; Ketabchi, N.; Derakhshan, M.A.; Babadi, A.A. Application of Electrospun Nanofibrous PHBV Scaffold in Neural Graft and Regeneration: A Mini-Review. Nanomed. Res. J. 2016, 1, 107–111. [Google Scholar] [CrossRef]
- Karbowniczek, J.E.; Kaniuk, Ł.; Berniak, K.; Gruszczyński, A.; Stachewicz, U. Enhanced Cells Anchoring to Electrospun Hybrid Scaffolds with PHBV and HA Particles for Bone Tissue Regeneration. Front. Bioeng. Biotechnol. 2021, 9, 632029. [Google Scholar] [CrossRef]
- Kaniuk, Ł.; Stachewicz, U. Development and Advantages of Biodegradable PHA Polymers Based on Electrospun PHBV Fibers for Tissue Engineering and Other Biomedical Applications. ACS Biomater. Sci. Eng. 2021, 7, 5339–5362. [Google Scholar] [CrossRef] [PubMed]
- Muigano, M.N.; Anami, S.E.; Onguso, J.M.; Mauti, G.O. Optimized Poly(3-Hydroxybutyrate-Co-3-Hydroxyvalerate) (PHBV) Production by Moderately Haloalkaliphilic Bacterium Halomonas Alkalicola Ext. Int. J. Polym. Sci. 2024, 2024, 6667843. [Google Scholar] [CrossRef]
- Kansiz, M.; Domínguez-Vidal, A.; McNaughton, D.; Lendl, B. Fourier-Transform Infrared (FTIR) Spectroscopy for Monitoring and Determining the Degree of Crystallisation of Polyhydroxyalkanoates (PHAs). Anal. Bioanal. Chem. 2007, 388, 1207–1213. [Google Scholar] [CrossRef] [PubMed]
- Bossu, J.; Angellier-Coussy, H.; Totee, C.; Matos, M.; Reis, M.; Guillard, V. Effect of the Molecular Structure of Poly(3-Hydroxybutyrate-Co-3-Hydroxyvalerate) (P(3HB-3HV)) Produced from Mixed Bacterial Cultures on Its Crystallization and Mechanical Properties. Biomacromolecules 2020, 21, 4709–4723. [Google Scholar] [CrossRef] [PubMed]
- Pramanik, N.; Das, R.; Rath, T.; Kundu, P.P. Microbial Degradation of Linseed Oil-Based Elastomer and Subsequent Accumulation of Poly(3-Hydroxybutyrate-Co-3-Hydroxyvalerate) Copolymer. Appl. Biochem. Biotechnol. 2014, 174, 1613–1630. [Google Scholar] [CrossRef] [PubMed]
- Bayari, S.; Severcan, F. FTIR Study of Biodegradable Biopolymers: P(3HB), P(3HB-Co-4HB) and P(3HB-Co-3HV). J. Mol. Struct. 2005, 744, 529–534. [Google Scholar] [CrossRef]
- Pradhan, S.; Dikshit, P.K.; Moholkar, V.S. Production, Ultrasonic Extraction, and Characterization of Poly (3-Hydroxybutyrate) (PHB) Using Bacillus Megaterium and Cupriavidus Necator. Polym. Adv. Technol. 2018, 29, 2392–2400. [Google Scholar] [CrossRef]
- Yu, W.; Lan, C.H.; Wang, S.J.; Fang, P.F.; Sun, Y.M. Influence of Zinc Oxide Nanoparticles on the Crystallization Behavior of Electrospun Poly(3-Hydroxybutyrate-Co-3-Hydroxyvalerate) Nanofibers. Polymer 2010, 51, 2403–2409. [Google Scholar] [CrossRef]
- Xu, Y.; Zou, L.; Lu, H.; Wei, Y.; Hua, J.; Chen, S. Preparation and Characterization of Electrospun PHBV/PEO Mats: The Role of Solvent and PEO Component. J. Mater. Sci. 2016, 51, 5695–5711. [Google Scholar] [CrossRef]
- Ivanova, G.; Serafim, L.S.; Lemos, P.C.; Ramos, A.M.; Reis, M.A.M.; Cabrita, E.J. Influence of Feeding Strategies of Mixed Microbial Cultures on the Chemical Composition and Microstructure of Copolyesters P(3HB-Co-3HV) Analyzed by NMR and Statistical Analysis. Magn. Reson. Chem. 2009, 47, 497–504. [Google Scholar] [CrossRef] [PubMed]
- Žagar, E.; Kržan, A.; Adamus, G.; Kowalczuk, M. Sequence Distribution in Microbial Poly(3-Hydroxybutyrate-Co-3-Hydroxyvalerate) Co-Polyesters Determined by NMR and MS. Biomacromolecules 2006, 7, 2210–2216. [Google Scholar] [CrossRef]
- Montiel-Jarillo, G.; Morales-Urrea, D.A.; Contreras, E.M.; López-Córdoba, A.; Gómez-Pachón, E.Y.; Carrera, J.; Suárez-Ojeda, M.E. Improvement of the Polyhydroxyalkanoates Recovery from Mixed Microbial Cultures Using Sodium Hypochlorite Pre-Treatment Coupled with Solvent Extraction. Polymers 2022, 14, 3938. [Google Scholar] [CrossRef]
- Cheng, H.N.; Biswas, A.; Vermillion, K.; Melendez-Rodriguez, B.; Lagaron, J.M. NMR Analysis and Triad Sequence Distributions of Poly(3-Hydroxybutyrate-Co-3-Hydroxyvalerate). Polym. Test. 2020, 90, 106754. [Google Scholar] [CrossRef]
- Yoshie, N.; Menju, H.; Sato, H.; Inoue, Y. Complex Composition Distribution of Poly(3-Hydroxybutyrate-Co-3-Hydroxyvalerate). Macromolecules 1995, 28, 6516–6521. [Google Scholar] [CrossRef]
- Gunaratne, L.M.W.K.; Shanks, R.A. Multiple Melting Behaviour of Poly(3-Hydroxybutyrate-Co-Hydroxyvalerate) Using Step-Scan DSC. Eur. Polym. J. 2005, 41, 2980–2988. [Google Scholar] [CrossRef]
- Guho, N.M.; Pokhrel, D.; Abbasi, M.; Mcdonald, A.G.; Alfaro, M.; Brinkman, C.K.; Coats, E.R. Pilot-Scale Production of Poly-3-Hydroxybutyrate-Co-3-Hydroxyvalerate from Fermented Dairy Manure: 1 Process Performance, Polymer Characterization, and Scale-up Implications. Bioresour. Technol. 2020, 12, 100588. [Google Scholar] [CrossRef]
- Tong, H.W.; Wang, M. Electrospinning of Poly(Hydroxybutyrate-Co-Hydroxyvalerate) Fibrous Scaffolds for Tissue Engineering Applications: Effects of Electrospinning Parameters and Solution Properties. J. Macromol. Sci. Part B Phys. 2011, 50, 1535–1558. [Google Scholar] [CrossRef]
- Tong, H.W.; Wang, M. Effects of Processing Parameters on the Morphology and Size of Electrospun PHBV Micro- and Nano-Fibers. Key Eng. Mater. 2007, 334, 1233–1236. [Google Scholar] [CrossRef]
- Tong, H.-W.; Wang, M. Electrospinning of Fibrous Polymer Scaffolds Using Positive Voltage or Negative Voltage: A Comparative Study. Biomed. Mater. 2010, 5, 054110. [Google Scholar] [CrossRef] [PubMed]
- Tong, H.W.; Wang, M.; Lu, W.W. Electrospun Poly(Hydroxybutyrate-Co-Hydroxyvalerate) Fibrous Membranes Consisting of Parallel-Aligned Fibers or Cross-Aligned Fibers: Characterization and Biological Evaluation. J. Biomater. Sci. Polym. Ed. 2011, 22, 2475–2497. [Google Scholar] [CrossRef] [PubMed]
- Tong, H.W.; Wang, M.; Lu, W.W. Electrospinning and Evaluation of PHBV-Based Tissue Engineering Scaffolds with Different Fibre Diameters, Surface Topography and Compositions. J. Biomater. Sci. Polym. Ed. 2012, 23, 779–806. [Google Scholar] [CrossRef] [PubMed]
- Suwantong, O.; Waleetorncheepsawat, S.; Sanchavanakit, N.; Pavasant, P.; Cheepsunthorn, P.; Bunaprasert, T.; Supaphol, P. In Vitro Biocompatibility of Electrospun Poly(3-Hydroxybutyrate) and Poly(3-Hydroxybutyrate-Co-3-Hydroxyvalerate) Fiber Mats. Int. J. Biol. Macromol. 2007, 40, 217–223. [Google Scholar] [CrossRef]
- Sombatmankhong, K.; Sanchavanakit, N.; Pavasant, P.; Supaphol, P. Bone Scaffolds from Electrospun Fiber Mats of Poly(3-Hydroxybutyrate), Poly(3-Hydroxybutyrate-Co-3-Hydroxyvalerate) and Their Blend. Polymer 2007, 48, 1419–1427. [Google Scholar] [CrossRef]
- Kaniuk, Ł.; Krysiak, Z.J.; Metwally, S.; Stachewicz, U. Osteoblasts and Fibroblasts Attachment to Poly(3-Hydroxybutyric Acid-Co-3-Hydrovaleric Acid) (PHBV) Film and Electrospun Scaffolds. Mater. Sci. Eng. C 2020, 110, 110668. [Google Scholar] [CrossRef]
- Kouhi, M.; Prabhakaran, M.P.; Shamanian, M.; Fathi, M.; Morshed, M.; Ramakrishna, S. Electrospun PHBV Nanofibers Containing HA and Bredigite Nanoparticles: Fabrication, Characterization and Evaluation of Mechanical Properties and Bioactivity. Compos. Sci. Technol. 2015, 121, 115–122. [Google Scholar] [CrossRef]
- Zhang, S.; Prabhakaran, M.P.; Qin, X.; Ramakrishna, S. Biocomposite Scaffolds for Bone Regeneration: Role of Chitosan and Hydroxyapatite within Poly-3-Hydroxybutyrate-Co-3-Hydroxyvalerate on Mechanical Properties and in Vitro Evaluation. J. Mech. Behav. Biomed. Mater. 2015, 51, 88–98. [Google Scholar] [CrossRef] [PubMed]
- Meng, W.; Kim, S.Y.; Yuan, J.; Kim, J.C.; Kwon, O.H.; Kawazoe, N.; Chen, G.; Ito, Y.; Kang, I.K. Electrospun PHBV/Collagen Composite Nanofibrous Scaffolds for Tissue Engineering. J. Biomater. Sci. Polym. Ed. 2007, 18, 81–94. [Google Scholar] [CrossRef] [PubMed]
- Lee, I.S.; Kwon, O.H.; Meng, W.; Kang, I.K.; Ito, Y. Nanofabrication of Microbial Polyester by Electrospinning Promotes Cell Attachment. Macromol. Res. 2004, 12, 374–378. [Google Scholar] [CrossRef]
- Ito, Y.; Hasuda, H.; Kamitakahara, M.; Ohtsuki, C.; Tanihara, M.; Kang, I.K.; Kwon, O.H. A Composite of Hydroxyapatite with Electrospun Biodegradable Nanofibers as a Tissue Engineering Material. J. Biosci. Bioeng. 2005, 100, 43–49. [Google Scholar] [CrossRef] [PubMed]
- Kaniuk, Ł.; Berniak, K.; Lichawska-Cieślar, A.; Jura, J.; Karbowniczek, J.E.; Stachewicz, U. Accelerated Wound Closure Rate by Hyaluronic Acid Release from Coated PHBV Electrospun Fiber Scaffolds. J. Drug Deliv. Sci. Technol. 2022, 77, 103855. [Google Scholar] [CrossRef]
- Dinos, G.P.; Athanassopoulos, C.M.; Missiri, D.A.; Giannopoulou, P.C.; Vlachogiannis, I.A.; Papadopoulos, G.E.; Papaioannou, D.; Kalpaxis, D.L. Chloramphenicol Derivatives as Antibacterial and Anticancer Agents: Historic Problems and Current Solutions. Antibiotics 2016, 5, 20. [Google Scholar] [CrossRef]
- Pramanik, U.; Khamari, L.; Shekhar, S.; Mukherjee, S. On the Role of Hydrophobic Interactions between Chloramphenicol and Bovine Pancreatic Trypsin: The Effect of a Strong Electrolyte. Chem. Phys. Lett. 2020, 742, 137137. [Google Scholar] [CrossRef]
- Miller, S.I. Antibiotic Resistance and Regulation of the Gram-Negative Bacterial Outer Membrane Barrier by Host Innate Immune Molecules. mBio 2016, 7, 10–1128. [Google Scholar] [CrossRef] [PubMed]
- Lemes, A.P.; Montanheiro, T.L.D.A.; Durán, N.; da Silva, A.P. PHBV/MWCNT films: Hydrophobicity, thermal and mechanical properties as a function of MWCNT concentration. J. Compos. Sci. 2019, 3, 12. [Google Scholar] [CrossRef]
- Khamplod, T.; Winterburn, J.B.; Cartmell, S.H. Electrospun Poly(3-Hydroxybutyrate-Co-3-Hydroxyvalerate) Scaffolds–a Step towards Ligament Repair Applications. Sci. Technol. Adv. Mater. 2022, 23, 895–910. [Google Scholar] [CrossRef] [PubMed]
- Rivas, M.; Del Valle, L.J.; Rodríguez-Rivero, A.M.; Turon, P.; Puiggalí, J.; Alemán, C. Loading of Antibiotic into biocoated hydroxyapatite nanoparticles: Smart antitumor platforms with regulated release. ACS Biomater. Sci. Eng. 2018, 4, 3234–3245. [Google Scholar] [CrossRef] [PubMed]
- Rosengart, A.; Cesário, M.T.; de Almeida, M.C.M.D.; Raposo, R.S.; Espert, A.; de Apodaca, E.D.; da Fonseca, M.M.R. Efficient P(3HB) Extraction from Burkholderia Sacchari Cells Using Non-Chlorinated Solvents. Biochem. Eng. J. 2015, 103, 39–46. [Google Scholar] [CrossRef]
- Barham, P.J.; Keller, A.; Otun, E.L.; Wills, H.H.; Holmes, P.A. Crystallization and morphology of a bacterial thermoplastic: Poly-3-hydroxybutyrate. J. Mater. Sci. 1984, 19, 2781–2794. [Google Scholar] [CrossRef]
- Jun, Z.; Hou, H.; Schaper, A.; Wendorff, J.H.; Greiner, A. Poly-L-lactide nanofibers by electrospinning–Influence of solution viscosity and electrical conductivity on fiber diameter and fiber morphology. e-Polymers 2003, 3, 009. [Google Scholar] [CrossRef]
- Ol’khov, A.A.; Staroverova, O.V.; Gol’dshtrakh, M.A.; Khvatov, A.V.; Gumargalieva, K.Z.; Iordanskii, A.L. Electrospinning of Biodegradable Poly-3-Hydroxybutyrate. Effect of the Characteristics of the Polymer Solution. Russ. J. Phys. Chem. B 2016, 10, 830–838. [Google Scholar] [CrossRef]

| Samples | d(020) | d(220) | d(111) | a (nm) | b (nm) | c (nm) |
|---|---|---|---|---|---|---|
| 7HV_Milk | 0.670 | 0.531 | 0.401 | 0.578 | 1.339 | 0.611 |
| 7HV_Molasses | 0.654 | 0.524 | 0.392 | 0.572 | 1.308 | 0.591 |
| 15HV_Milk | 0.667 | 0.532 | 0.405 | 0.580 | 1.334 | 0.625 |
| 15HV_Molasses | 0.657 | 0.526 | 0.402 | 0.574 | 1.314 | 0.623 |
| 32HV_Milk | 0.665 | 0.534 | 0.410 | 0.583 | 1.330 | 0.640 |
| 32HV_Molasses | 0.663 | 0.530 | 0.413 | 0.578 | 1.326 | 0.659 |
| Samples | Monomer Mole Fraction a | Diad Mole Fraction b | D Parameter | ||||
|---|---|---|---|---|---|---|---|
| FB | FV | FBB | FBV | FVB | FVV | ||
| 7HV_Milk | 0.934 | 0.066 | 0.870 | 0.064 | 0.055 | 0.011 | 2.80 |
| 7HV_Molasses | 0.931 | 0.069 | 0.831 | 0.081 | 0.077 | 0.011 | 1.42 |
| 15HV_Milk | 0.853 | 0.147 | 0.862 | 0.059 | 0.056 | 0.024 | 6.32 |
| 15HV_Molasses | 0.851 | 0.149 | 0.786 | 0.096 | 0.089 | 0.029 | 2.67 |
| 32HV_Milk | 0.682 | 0.318 | 0.450 | 0.222 | 0.213 | 0.115 | 1.10 |
| 32HV_Molasses | 0.683 | 0.317 | 0.449 | 0.223 | 0.213 | 0.114 | 1.08 |
| Samples | Modulus E (MPa) | Tensile Strength (MPa) | Elongation at Break (%) |
|---|---|---|---|
| 7HV_Milk | 1277 ± 39 | 18.1 ± 0.3 | 4.3 ± 2.5 |
| 7HV_Molasses | 1129 ± 51 | 16.5 ± 0.4 | 4.1 ± 2.4 |
| 15HV_Milk | 920 ± 53 | 17.0 ± 0.4 | 8.1 ± 3.2 |
| 15HV_Molasses | 823 ± 47 | 16.1 ± 0.4 | 15.6 ± 3.1 |
| 32HV_Milk | 312 ± 59 | 7.1 ± 0.6 | 95.1 ± 8.1 |
| 32HV_Molasses | 230 ± 51 | 5.0 ± 0.5 | 102.4 ± 7.1 |
| Samples | Solution Concentration (% w/v) | Applied Voltage (kV) | Feeding Rate (mL/h) | Fiber Diameter (µm) |
|---|---|---|---|---|
| 7HV_Milk | 10 | 15 | 2 | 2.14 ± 0.27 |
| 7HV_Molasses | 10 | 15 | 2 | 2.49 ± 0.24 |
| 15HV_Milk | 15 | 15 | 2 | 2.34 ± 0.30 |
| 15HV_Molasses | 15 | 15 | 2 | 2.29 ± 0.35 |
| 32HV_Milk | 20 | 15 | 2 | 2.91 ± 0.37 |
| 32HV_Molasses | 20 | 15 | 2 | 2.70 ± 0.43 |
Disclaimer/Publisher’s Note: The statements, opinions and data contained in all publications are solely those of the individual author(s) and contributor(s) and not of MDPI and/or the editor(s). MDPI and/or the editor(s) disclaim responsibility for any injury to people or property resulting from any ideas, methods, instructions or products referred to in the content. |
© 2024 by the authors. Licensee MDPI, Basel, Switzerland. This article is an open access article distributed under the terms and conditions of the Creative Commons Attribution (CC BY) license (https://creativecommons.org/licenses/by/4.0/).
Share and Cite
Jin, A.; Pérez, G.; Martínez de Ilarduya, A.; del Valle, L.J.; Puiggalí, J. Characterization and Biomedical Applications of Electrospun PHBV Scaffolds Derived from Organic Residues. Int. J. Mol. Sci. 2025, 26, 180. https://doi.org/10.3390/ijms26010180
Jin A, Pérez G, Martínez de Ilarduya A, del Valle LJ, Puiggalí J. Characterization and Biomedical Applications of Electrospun PHBV Scaffolds Derived from Organic Residues. International Journal of Molecular Sciences. 2025; 26(1):180. https://doi.org/10.3390/ijms26010180
Chicago/Turabian StyleJin, Anyi, Germán Pérez, Antxon Martínez de Ilarduya, Luis J. del Valle, and Jordi Puiggalí. 2025. "Characterization and Biomedical Applications of Electrospun PHBV Scaffolds Derived from Organic Residues" International Journal of Molecular Sciences 26, no. 1: 180. https://doi.org/10.3390/ijms26010180
APA StyleJin, A., Pérez, G., Martínez de Ilarduya, A., del Valle, L. J., & Puiggalí, J. (2025). Characterization and Biomedical Applications of Electrospun PHBV Scaffolds Derived from Organic Residues. International Journal of Molecular Sciences, 26(1), 180. https://doi.org/10.3390/ijms26010180

